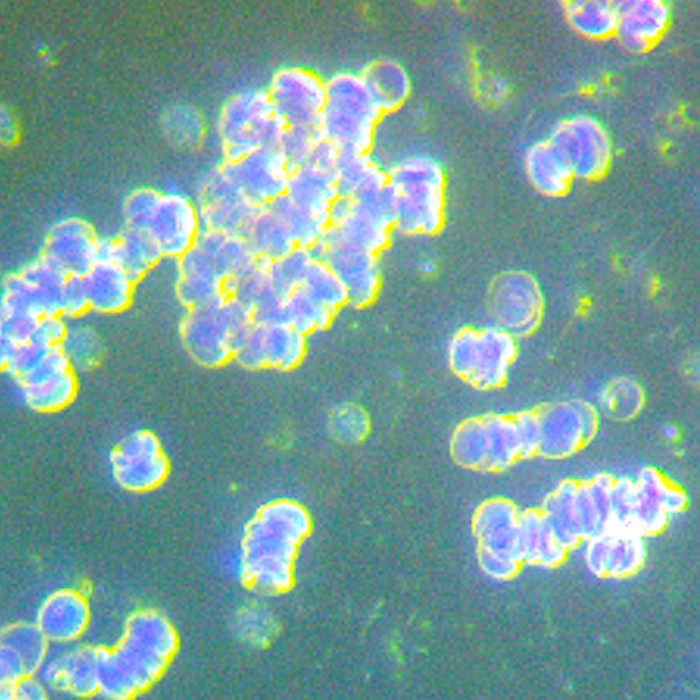
before meditation darkfield microscopy life under the lens
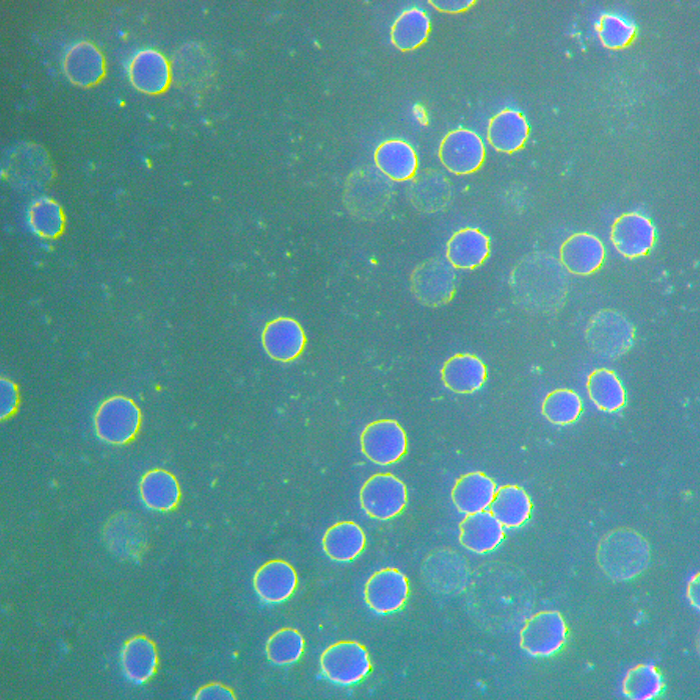
after meditation darkfield microscopy life under the lens

The following two images were taken just thirty minutes apart.
The first shows red blood cells (RBCs) in a state of rouleaux formation — stacked and clumped together like rolls of coins. When blood cells behave this way, circulation can become sluggish, oxygen delivery is reduced, and the body’s tissues may receive less nourishment.

The second image, taken after a short meditation session, shows a remarkable change. The red blood cells have returned to their natural free-flowing state, moving independently and evenly dispersed. This is the optimal condition for circulation, where blood can deliver oxygen and nutrients efficiently throughout the body.
Another interesting feature is the presence of dark, round cells scattered among the red blood cells. These are most likely lymphocytes — a type of white blood cell central to the immune system. The higher number observed here suggests the immune system is active, potentially responding to a stressor or threat.
What makes this comparison striking is that such a clear improvement occurred after only half an hour of meditation. It highlights how profoundly the mind and body are connected, and how practices that reduce stress and promote calm can have measurable effects at the cellular level.
This is not a diagnostic test, but it is a fascinating window into how lifestyle choices — in this case, something as simple as mindful stillness — can influence the living terrain of the blood.
 Disclaimer
Disclaimer